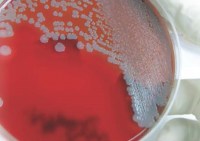
PLS and Complexity

White Papers
PLS and Complexity
PLS and Complexity
For this Pathology focussed, short white paper, I was responsible for the design and for putting together the copy from a draft written by a Pathology colleague.
 The Fundamentals of Mobile Radiology
The Fundamentals of Mobile Radiology
This white paper on the basics of using Radiology Information Systems via mobile applications for smart phones and tablets promoted the benefits of the Karisma iOS application.
 5 Benefits of Tracking Inventory
5 Benefits of Tracking Inventory
This white paper on the benefits of tracking inventory across organisations was written to promote the Inventory features of Karisma version 3 to existing clients about to receive an upgrade.
 Medicare: What’s in an Upgrade?
Medicare: What’s in an Upgrade?
This white paper on the process of updating Medicare Online for Karisma clients was written by the Support Manager at Kestral and then proofread/edited and designed by me for publication.
Resources
 SpeechMagic Shortcut Commands
SpeechMagic Shortcut Commands
This handy reference guide was created to assist users when utilising SpeechMagic voice recognition integration with Karisma. The large number of shortcuts for the program are defined in a table format over three pages.
 PLS Infrastructure Overview
PLS Infrastructure Overview
This technical overview of the Pathology Laboratory System (PLS) outlines the main components of the program, the client and server details for the database and add-on features such as HLConnect.
 Karisma v3 Help File
Karisma v3 Help File
My ongoing technical writing project at Kestral, given how the program is updated frequently, the Karisma v3 Help file consists of more than 1000 pages of step by step information on using Karisma. All help contained in the file was written and compiled by me.